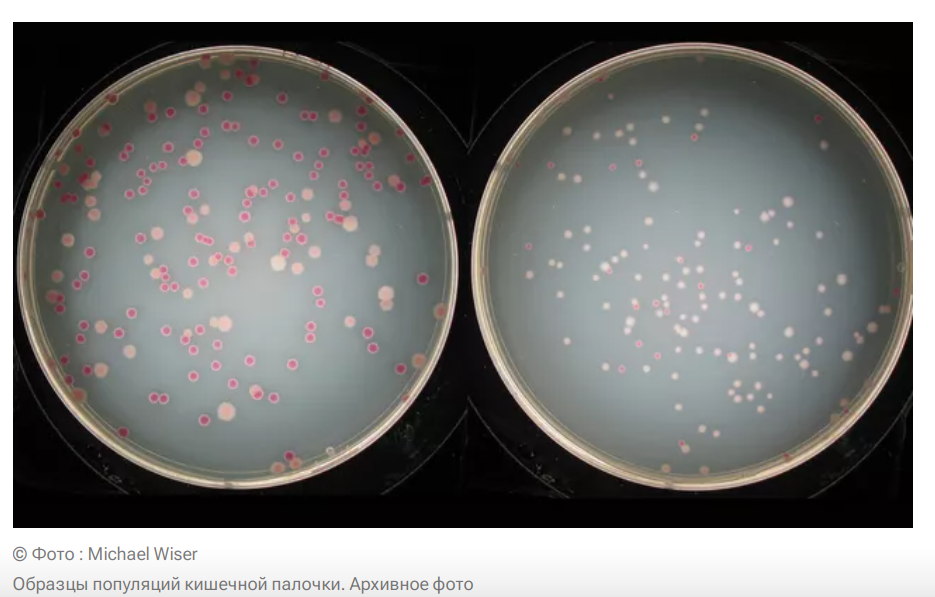

| Главная » Статьи » Житейские советы | [ Добавить статью ] |
| В категории материалов: 8046 Показано материалов: 1701-1750 |
Страницы: « 1 2 ... 33 34 35 36 37 ... 160 161 » |
Сортировать по: Дате · Названию · Рейтингу · Комментариям · Просмотрам
Военные пенсионеры